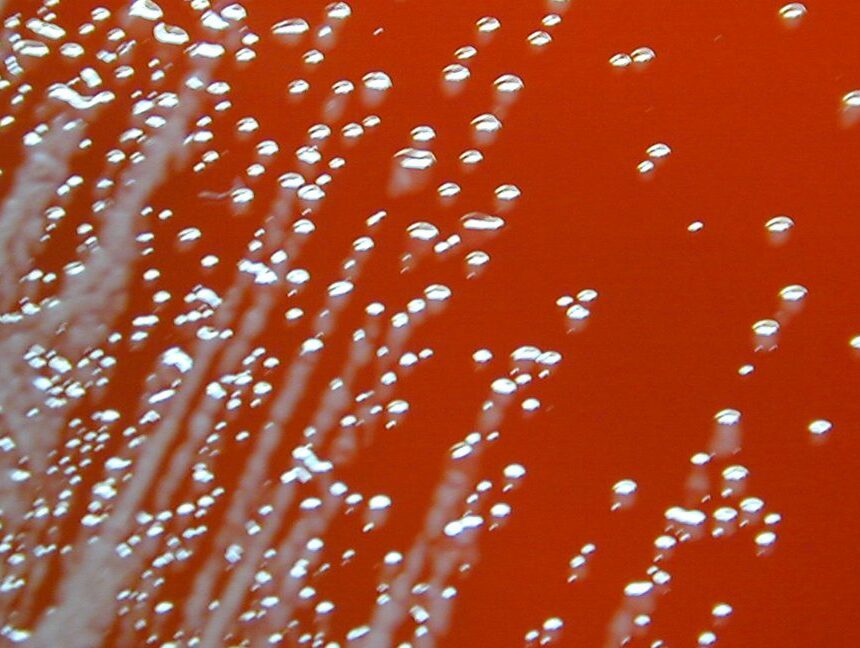
GettyImages_Burkholderia_CROPPED-1152x648.jpeg Deux hommes sont tombés gravement malades l’année dernière ; leurs infections sont liées à des décès survenus dans les années 80

La récente résistance Les travaux universitaires sur la question de l’activisme anti-éolien révèlent un modèle : La pensée conspirationniste est un facteur prédictif de l’opposition plus fort que l’âge, le sexe, l’éducation ou l’orientation politique. En Allemagne, l’universitaire Kevin Winter et ses collègues ont constaté que la croyance en des complots avait beaucoup plus d’influence sur l’opposition à l’éolien que...

Le GOP du Texas adopte le remaniement de la Chambre des représentants demandé par Trump
Les républicains du Texas ont approuvé tôt samedi matin une nouvelle carte du Congrès qui comporte des divisions agressives, allant ainsi de l’avant avec une prise de pouvoir voulue par le président Donald Trump. Le Sénat de l’État, contrôlé par le GOP, a approuvé la carte lors d’un vote sur une ligne de parti après des heures de débat qui...

Le gouvernement américain prend une participation de 10 % dans Intel dans le cadre d’une tentative inhabituelle de relance de la fabrication de puces.
Le président Trump et Intel ont annoncé vendredi un accord qui donnera au gouvernement américain une participation de 10 % dans la société. Cette participation passive n’inclura pas de représentation au conseil d’administration, mais des accords similaires entre l’État et d’autres entreprises technologiques pourraient se profiler à l’horizon.Lire l’intégralité de l’article

Blanar et Szijjarto ont envoyé une lettre ouverte à Kallas concernant les attaques de l’Ukraine contre l’oléoduc de Druzhba.
Bratislava/Budapest, 22 août (TASR) – L’armée ukrainienne a attaqué l’infrastructure de l’oléoduc Druzhba sur le territoire russe à trois reprises en neuf jours, entraînant une suspension des approvisionnements par l’oléoduc qui transporte le pétrole vers la Slovaquie et la Hongrie. Les ministres des affaires étrangères de la Slovaquie et de la Hongrie, Juraj Blanár et Péter Szijjártó, ont donc envoyé...

Les mots « woke » que les démocrates devraient supprimer de leur vocabulaire
Les démocrates semblent penser qu’ils peuvent parler pour sortir du désert politique. Écoutez attentivement et vous pourrez l’entendre à travers le vacarme de leurs flux X Trumpiens en majuscules, de leurs interviews en podcast de la « manosphère » qui durent des heures et de leurs jurons de plus en plus fréquents. Près de 10 mois après les élections de 2024, le...
Deux hommes sont tombés gravement malades l’année dernière ; leurs infections sont liées à des décès survenus dans les années 80
Les médecins ont rapidement découvert qu’ils étaient infectés par une bactérie rare du sol, qui provoque une maladie appelée mélioïdose. Une infection dangereuse En général, la mélioïdose peut être difficile à diagnostiquer et à traiter, car elle est naturellement résistante à certains antibiotiques. Elle peut infecter les personnes qui l’inhalent ou qui l’introduisent dans des coupures ouvertes. Parfois, l’infection peut...

L’Union européenne et le Conseil de l’Europe en Bosnie-Herzégovine poursuivent leurs activités dans le cadre de l’initiative « Block Hate. Partager l’amour
Sarajevo, (Fena) – La deuxième phase de l’initiative conjointe de l’Union européenne et du Conseil de l’Europe « Bloquez la haine. Partager l’amour ! 2.0 » a officiellement débuté le jeudi 21 août par un tournoi de football pour enfants au stade FK Sloga de Vukosavlje, où des garçons et des filles de cinq municipalités se sont rassemblés pour promouvoir la...

L’interdiction de téléphoner à l’école s’étend à 17 nouveaux États
Dix-sept États et le district de Columbia ont commencé cette année scolaire en imposant de nouvelles limites à l’utilisation des téléphones portables par les élèves, marquant ainsi l’une des tendances les plus rapides de la politique éducative américaine. Avec les derniers ajouts, un total de 35 États disposent désormais de lois ou de règles limitant l’utilisation des téléphones et autres...

Le téléviseur « Micro RGB » de Samsung prouve la valeur des rétroéclairages RVB pour les écrans haut de gamme
Samsung a refusé de préciser le type de panneau LCD utilisé dans le téléviseur, mais a indiqué qu’il s’agissait du même type que celui utilisé dans ses autres téléviseurs QLED. Scharon Harding Samsung a refusé de préciser le type de panneau LCD utilisé dans le téléviseur, mais a indiqué qu’il s’agissait du même type que celui utilisé dans ses autres...

Landsbergis : « Un mauvais accord en Ukraine rendra l’Europe de l’Est plus vulnérable ».
BRUXELLES – Un « mauvais accord » en Ukraine, en particulier avec la reconnaissance de l’occupation russe dans de grandes parties du pays, bien que « de facto et non de jure », « réduirait l’influence américaine en Europe de l’Est » et « sèmerait le doute » quant à la volonté de l’OTAN de protéger l’ensemble du flanc oriental, en particulier pour les régions, telles que les...
